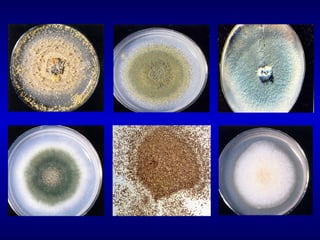

El documento trata sobre las micosis oportunistas causadas por los hongos Aspergillus spp. y los hongos del género Mucorales. Aspergillus fumigatus, A. niger, A. terreus y A. flavus son las especies de Aspergillus más patógenas para los humanos. Las infecciones por estos hongos incluyen aspergilosis pulmonar, diseminada y cutánea. La cigomicosis es causada por hongos como Rhizopus, Mucor y Absidia, y puede manifestarse como in